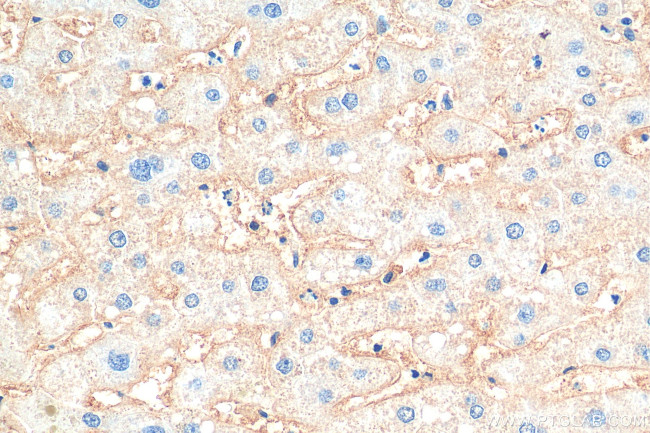
CD81 Antibody in Immunohistochemistry (Paraffin) (IHC (P))

Search
Proteintech
CD81 Monoclonal Antibody (1G2C6), Biotin Plus
{{$productOrderCtrl.translations['antibody.pdp.commerceCard.promotion.promotions']}}
{{$productOrderCtrl.translations['antibody.pdp.commerceCard.promotion.viewpromo']}}
{{$productOrderCtrl.translations['antibody.pdp.commerceCard.promotion.promocode']}}: {{promo.promoCode}} {{promo.promoTitle}} {{promo.promoDescription}}. {{$productOrderCtrl.translations['antibody.pdp.commerceCard.promotion.learnmore']}}
产品信息
BIOTIN-66866
种属反应
宿主/亚型
分类
类型
克隆号
抗原
偶联物
形式
纯化类型
保存液
内含物
保存条件
运输条件
产品详细信息
Immunogen sequence: VNKDQIAKDV KQFYDQALQQ AVVDDDANNA KAVVKTFHET LDCCGSSTLT ALTTSVLKNN LCPSGSNIIS NLFKEDCHQK IDDLFS
靶标信息
CD81 (TAPA-1, target of anti-proliferative antibody-1) is a member of the tetraspanin family, is expressed on virtually all nucleated cells, but above all on germinal center B cells. CD81 forms complexes with other tetraspanin proteins, integrins, coreceptors, MHC class I and II molecules, and influences adhesion, morphology, activation, proliferation and differentiation of B, T cells. In muscles, CD81 promotes cell fusion and myotube maintenance. CD81 has been also identified as a receptor for the hepatitis C virus. Like members of the tetraspanin family that include CD9, CD37, CD53, CD63, and CD82, CD81 is a cell-surface proteins that are characterized by the presence of four hydrophobic domains. The proteins mediate signal transduction events that play a role in the regulation of cell development, activation, growth and motility. CD81 is a cell surface glycoprotein that is known to complex with integrins. CD81 appears to promote muscle cell fusion and support myotube maintenance. CD81 associates with CD19, CD21, Leu 13, and integrins on cell membrane and acts as a receptor for the envelope protein E2 of chronic hepatitis C virus. Antibodies to CD81 have anti-proliferative effects on different lymphoid cell lines, particularly those derived from large cell lymphomas. CD81 is also localized in the tumor-suppressor gene region and is a candidate gene for malignancies.
仅用于科研。不用于诊断过程。未经明确授权不得转售。
篇参考文献 (0)
生物信息学
蛋白别名: 26 kDa cell surface protein TAPA-1; 26-kDa cell surface protein TAPA-1; CD81; CD81 antigen; CD81 antigen (target of antiproliferative antibody 1); Target of the antiproliferative antibody 1; Tetraspanin-28; Tetraspanin28; Tspan-28
基因别名: CD81; CVID6; S5.7; TAPA1; TSPAN28
UniProt ID: (Human) P60033
Entrez Gene ID: (Human) 975